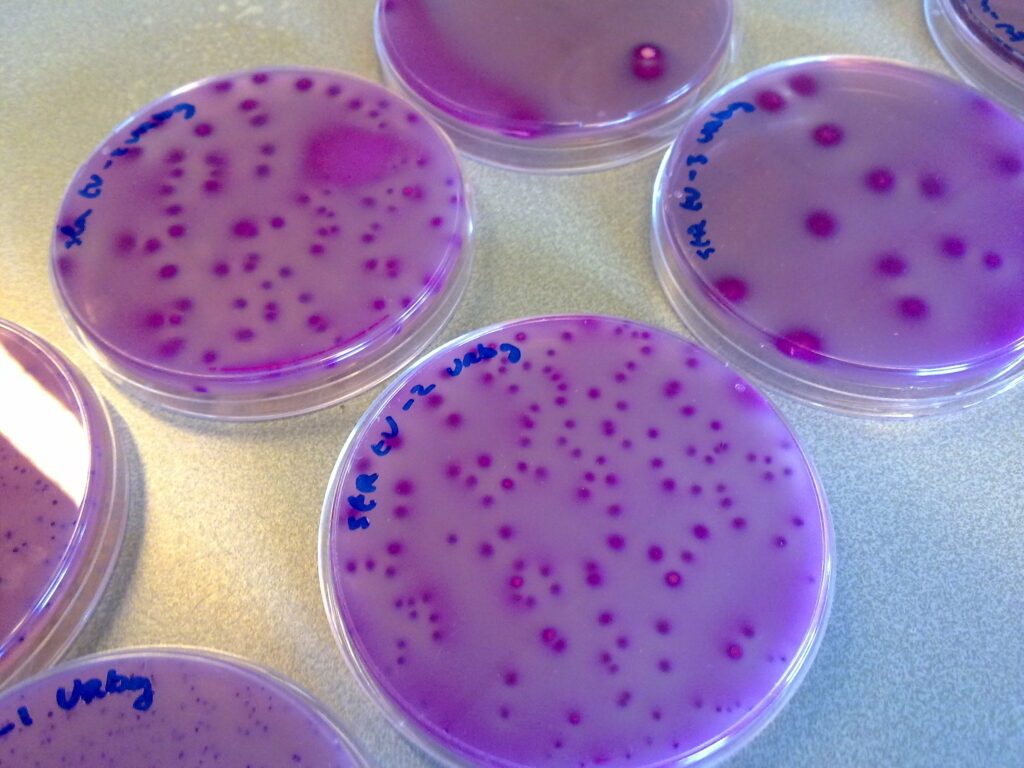

Deze zomer zijn 63 gevallen van besmetting met de STEC-bacterie gemeld bij uitbraken in woonzorgcentra in België. In totaal overleden acht personen aan deze voedselinfectie (VRT nieuws).
STEC staat voor Shiga-toxine producerende Escherichia coli. Dat is een bijzondere variant van de gewone E. coli-bacterie die normaal in onze darmen voorkomt. De STEC-variant kan het giftige Shiga-toxine aanmaken die de darmwand en soms ook de nieren beschadigt. Een goede hygiëne en een veilige omgang met voedsel in de keuken kan het risico op STEC en andere voedselinfecties flink verlagen.
Enterobacteriaceae
In de voedingsmiddelenmicrobiologie wordt vaak getest op Enterobacteriaceae, de familie bacteriën waartoe Escherichia coli behoort. Als Enterobacteriaceae worden aangetoond, kan dat wijzen op gebrekkige hygiëne of besmettingsrisico’s.
In de leermethode Basisvaardigheden Microbiologie is een experiment opgenomen waarmee het aantal Enterobacteriaceae wordt bepaald in kant-en-klaar maaltijden (exp. 47).